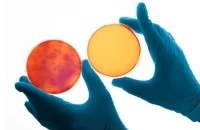
Microbial_limit
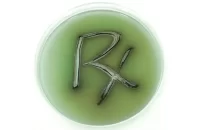
Pharmaceutical_testing
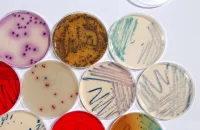
all-application-moltox

MOLTOX
MOLTOX® manufactures products used in mutagenicity tests. Our products and services for human risk assessment include MOLTOX® minimal glucose agar plates, top agars, Salmonella and E. coli tester strains, frozen and lyophilized S9, MUTAZYME™, NADPH-regenerating systems and positive control chemicals.

Over 35 Years of Trusted Manufacturing

Customized Formulations and Private Label Packaging

Prepared Media Reagents Genetic Toxicology

MOLTOX® manufactures products used in mutagenicity tests. Our products and services for human risk assessment include MOLTOX® minimal glucose agar plates, top agars, Salmonella and E. coli tester strains, frozen and lyophilized S9, MUTAZYME™, NADPH-regenerating systems and positive control chemicals. MOLTOX® offers Salmonella and E. coli test kits in plate incorporation and fluctuation test formats. We also provide our SOS/UMU assay kit, which is designed for use with solid and aqueous environmental samples.
Culture Media by Application
No matter what type of research application you are doing in your lab, MOLTOX® provides media for your needs. From Cosmetic to Water/Wasetwater testing, we manufacture quality products with exceptional industry competitive lead times.
More About MOLTOX
Product Spotlight Mitas Salivarious Agar Plates
Welcome EMGS Attendees! An introduction to MOLTOX! Please visit MOLTOX.com for all of your lab’s Genetic Toxicology needs and a list of our world wide distributor partners. Any additional inquires sale@site_85241c2f-cce4-410f-9645-9fceaf55e8b5 @environmentalmutagenesisan1405
Flyers and Product Guides
FAQ
Q1. What microbial detection and mutagenicity testing products does Moltox offer?
A. Moltox provides reference strains, S9 metabolic activation systems, and bacterial tester strains for Ames tests and genotoxicity assays.
Q2. How quickly can Moltox products reach Indian labs?
A. Standard lead time is 3–4 weeks. Shipments are temperature-controlled.
Q3. Are Moltox products validated for OECD or GLP testing?
A. Yes. Moltox is widely used by CROs and regulatory labs worldwide, and documentation is provided.
View More FAQs
Q1. What is mutagenicity/genotoxicity and how does the MOLTOX® Mutagenicity Assay Kit help?
A. Mutagenicity and genotoxicity measure DNA damage potential, and MOLTOX® kits enable Ames and related bacterial assays to assess this, ensuring chemical and drug safety.
Q2. Which bacterial strains are included in MOLTOX® kits?
A. Kits include Salmonella (TA1535, TA1537, TA98, TA100) and E. coli (WP2 trp, WP2 trp uvrA) strains, each detecting specific DNA damage and mutagenic activity.
Q3. What formats of MOLTOX® kits are available?
A. MOLTOX® kits are offered in plate-based (Ames, µAmes), liquid microtiter fluctuation (FT™), UMU genotoxicity, and phenotype confirmation formats.
Q4. How should MOLTOX® reagents be stored?
A. Most reagents are refrigerated, while sensitive chemicals like freeze-dried S9 mixes require ultra-low (-80°C) storage, following label instructions.
Q5. Can I customize my mutagenicity assay using MOLTOX®?
A. Yes, individual components like media, S9 mix, and test chemicals can be purchased separately to design assays tailored to laboratory needs.
Didn’t find your answer?
Ask us now.
The Krishgen support team strives to provide swift responses and resolution to your queries. Get in touch for a technical question, product query or quote request.